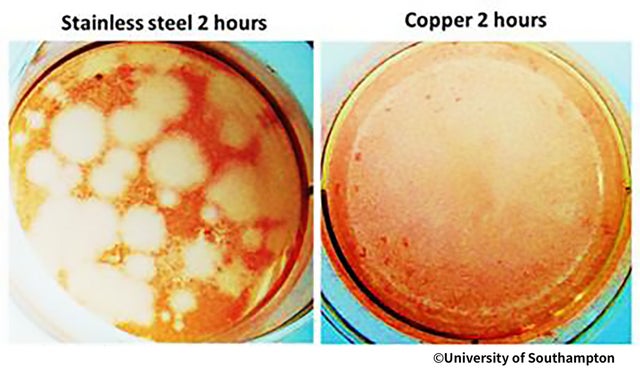

プロジェクト実行者
ストーリー
- 銅の力が生み出す、強力な「除菌・抗菌・消臭」マスク
- 年中快適!「速乾・冷却・UV遮断」AQUA-X新素材の呼吸しやすいマスク
- ノンホルムアルデヒド、26種類の成分安全検査済みで信頼の品質!




「銅DRYMASK」は、銅を繊維状にした生地を採用したマスクです。また、長い研究開発で生まれた新素材aqua-Xを採用し、それらの生地を合わせることで除菌、抗菌、消臭などの機能性と速乾性や高い蒸発機能により年中蒸れにくい快適性を兼ね備えたマスクです。


微量金属作用(Oligodynamic Action)ということをご存知でしょうか。
銅のほか金や銀にも同様の効果がみとめられていますが、その中で特に銅はわずかな量でも驚くほどの除菌・抗菌作用を発揮します。銅繊維の生地を採用することで清潔にお使い頂けるマスクです。


マスクを手洗いする際にしっかり洗えているか、乾いた後に嫌な匂いがするのではないかと心配する必要はないです!
耐久性に優れた生地で、何度洗濯しても、銅の強力な抗菌力で洗濯後でもキレイに乾き、爽やかさが続きます。
堅牢度という値が4−5(最大値)であり、生地の耐久性が強いといえます。


汗で蒸れたマスクはカビが発生し易くなります。
しかし、銅 DRY マスクは、カビにも強い抵抗性を持つからいつでも快適に使えるSafety Maskといえます。


空気よりも軽く、拡散性が高いアンモニアは、悪臭の原因と言われています。試験結果では、アンモニアを30分で72%、2時間で84%減少させることができ、銅DRYマスクが高い消臭力を持っていることが分かりました。

目で視て分かる!銅の力!
微生物は繰り返し分裂し増殖することで恐ろしい力を発揮します。それに対して銅は微生物等が活動しにくい自然な除菌・抗菌環境を作っていきます。
従来から、銅は様々な分野でその力が認められ、除菌・抗菌作用金属として活用されています。

微量金属作用(Oligodynamic Action)
この効果によって湖の汚れを改善したり、家庭の台所で使う三角コーナーや排水口ゴミキャッチャーを銅製のものにし、家庭排水をきれいにしようという活動が行われたこともあります。身近なところでは、切り花を長持ちさせるため、花瓶の中に10円玉を入れるという知恵が有名です。これは、水に溶け出た銅イオンがカビや細菌の繁殖を抑えるため、花が長持ちするといわれています。(Source:一般社団法人日本銅センターから)

もはやマスクは必須の時代。
無意識にマスクを触ってしまう!
なんと1時間毎に20回以上!
「マスクをしていれば安心」と思いがちです。しかし、本当のリスクはマスクを触ってしまうこと。ズレや蒸れが気になり、いつの間にかマスクを触ってしまうものです。折角マスクをしていても、汚染されたマスク表面を触ってしまうと手指が汚染されてしまいます。

世界保健機関(WHO)の発表によると、単にマスクを着用したから安心なわけではなく、手指の衛生を保ち、マスクをしている間にはマスク表面を絶対触らないこと。また、マスクを取り外す際には特に注意が必要とされております。しかし、2015年オーストラリア大学の研究によれば、人が無意識中にマスクを触る回数はなんと1時間毎に20回以上!これからは銅の力で清潔なマスクを使いましょう!


ホルマリンの一種であり、VOC(有害揮発性有機化合物)として有名なのがホルムアルデヒドです。よく塗料や合板などの製造に使われる接着剤に含まれており、空中に放散され、多量に吸い込むと目・鼻・喉の痛みやかゆみ、頭痛、ふらつき、皮膚のかゆみなどを引き起こします。そこで重要になってくるのが「ノンホルムアルデヒド」という概念です。本商品は、しっかりと素材の検査を行った、「ノンホルムアルデヒド」商品です。




肌に触れるものだから
毎日を一緒に過ごす
身近なものだからこそ
26種類の成分に関して徹底的に検査した素材を使用しました。


長い研究開発で生まれた新素材aqua-Xを採用し、速乾と高い蒸発機能により年中蒸れにくい快適なマスクが誕生しました。

汗にびっしょり濡れたマスクをずっと着けているのは嫌なものです。aqua-X素材の銅 DRY MASKは、汗を素早く乾かして、蒸れにくいマスクを実現しました。


地面が燃える様な猛烈な蒸し暑い夏や、暖房で暑苦しい冬の電車の中など、季節に関係なく人はいつでも汗をかきます。aqua-X素材の銅 DRY MASKは、汗を素早く吸収し、マスクと口の間が蒸れにくい環境を作ると共に吸収した水分を蒸発させ、水分の排出を大幅に助けます。

マスクを快適に使うためには、冷却だけでは足りません。aqua-X素材はUDF50+という優れたUV遮断力を持ち、強い日差しの下でも快適にご使用になれます。


口元にこもりやすい吐息の熱を素早く発散し、温度上昇を抑えることで、快適に着用頂けます。


銅の素材特性により、遠赤外線が放出されるため、冬には暖かく、かつ爽やかで年中快適に使えます。


高品質のストラップを採用し、長時間使用時の耳への負担を抑えました。また、ストラップの長さは簡単に調整可能です。






Detail Shot




仕 様
品名:マスク(商品名:銅 DRY MASK)
対象:風邪・花粉・ホコリなど
素材:aqua-X(約 ナイロン80%、ポリウレタン20%)、銅原糸
使用可能目安:洗濯後、繰り返し使用可能
商品重量(マスクのみ):12g
マスクサイズ:(約)縦14cm x 横(半径)10.5cm
製造国:大韓民国
販売者名:BnetSupport株式会社
※デザインや仕様は、品質向上のために変更になる場合がございます。
洗濯方法
1. 中性洗剤をぬるま湯で十分に溶かし、短時間つけてから優しく押し洗いしてください。
2. 洗剤が残らないよう、すすぎは十分に行ってください。
3. 脱水時は、ねじり絞りを避けて下さい。
4. 洗濯後は、形を整えて日陰で平干ししてください。
5. 生地にダメージを与えるため洗濯機の使用はお避けください。
使用後の保管及び管理方法
1. 高温多湿を避け、常温で保管してください。
2. 衛生上、他人との共用はお避け下さい。
メーカー情報
※本商品は、弊社BnetSupport株式会社が日本で企画し、開発および製造は韓国で行なっております。

生産メーカーは業界歴30年の繊維専門会社であり、独自の技術とノウハウを持っており繊維に関してはプロ中のプロです。アジア各国に輸出した実績もあり、近年では海外からOEMに関する問い合わせが相次ぐ程、その技術力と品質がたくさんのお客様から好評をいただいております。
実行者

私たちBnetSupport株式会社は、今回、銅マスクのメーカーと出会い、これからのアフターコロナ時代を克服するためにマクアケの会員様に銅DRYマスクをご紹介させて頂きたいと思います。昨今の品質の悪化や価格競争を中心とした製品ではなく、自信を持ってご紹介できる本物の商品をご提案致します。
リスク&チャレンジ
わたしたちは、銅DRYマスクを日本に輸入する為に、現在工場とデザイン・仕様を実現できるよう、プロジェクトを誠心誠意進めています。 しかしながら、開発中の工程において、デザイン・仕様が一部変更になる可能性もあります。 デザイン・仕様の変更はより良い商品を皆様のお手元に届けたいからであることご理解頂けると幸いです。使用感などに関しては、感じ方に個人差が予想される製品でございます。そのため、使用感等に関する返品・返金はお受けいたしかねます。 並行輸入品が発生する可能性があります。個人輸入及び販路によっては防ぐことができない可能性がある点、ご了承願います。 製造スケジュールについては、現在プロジェクト成功を想定した数で調整しておりますが、 ご支援数が想定を上回った場合、製造工程上の都合や配送作業に伴う止むを得ない事情により、 お届けが遅れる場合がございます。 上記のようにプロジェクトページに記載している内容に変更がある場合は、できるだけ早く活動レポートなどで共有を行っていく予定です。 最後に、銅DRYマスクを手に取った皆様に喜んで頂けるよう、チームメンバー一同心を込めて対応していきますので、宜しくお願い致します。
サポーターからの応援コメント
文章のトップに戻る
応援購入する
このプロジェクトはAll in型です。目標金額の達成に関わらず、プロジェクト終了日の2020年09月29日までに支払いを完了した時点で購入が成立します。
先着50名様!【黒3枚セット割】30%オフ、1800円引き

4,200円(税込)
・完成した商品×3点
(一般販売予定金額:6,000円(税込)の30%OFF)
送料込み
先着100名様!【白3枚セット割】25%オフ、1500円引き

4,500円(税込)
・完成した商品×3点
(一般販売予定金額:6,000円(税込)の25%OFF)
送料込み
先着100名様!【黒3枚セット割】25%オフ、1500円引き

4,500円(税込)
・完成した商品×3点
(一般販売予定金額:6,000円(税込)の25%OFF)
送料込み
先着300名様!【白3枚セット割】15%オフ、1200円引き

4,800円(税込)
・完成した商品×3点
(一般販売予定金額:6,000円(税込)の15%OFF)
送料込み
【マクアケ割】白3枚セット10%オフ

5,400円(税込)
・完成した商品×3点
(一般販売予定金額:6,000円(税込)の10%OFF)
送料込み
先着50名様!【白5枚セット割】30%オフ、3000円引き

7,000円(税込)
・完成した商品×5点
(一般販売予定金額:10,000円(税込)の30%OFF)
送料込み
先着100名様!【白5枚セット割】25%オフ、2500円引き

7,500円(税込)
・完成した商品×5点
(一般販売予定金額:10,000円(税込)の25%OFF)
送料込み
先着300名様!【白5枚セット割】15%オフ、2000円引き

8,000円(税込)
・完成した商品×5点
(一般販売予定金額:10,000円(税込)の15%OFF)
送料込み
【マクアケ割】白5枚セット10%オフ

9,000円(税込)
・完成した商品×5点
(一般販売予定金額:10,000円(税込)の10%OFF)
送料込み
先着50名様!【白10枚セット割】40%オフ、8000円引き

12,000円(税込)
・完成した商品×10点
(一般販売予定金額:20,000円(税込)の40%OFF)
送料込み
先着100名様!【白10枚セット割】35%オフ、7000円引き

13,000円(税込)
・完成した商品×10点
(一般販売予定金額:20,000円(税込)の35%OFF)
送料込み
先着50名様!【白3枚セット割】30%オフ、1800円引き

4,200円(税込)
・完成した商品×3点
(一般販売予定金額:6,000円(税込)の30%OFF)
送料込み
「Makuake(マクアケ)」は、実行者の想いを応援購入によって実現するアタラシイものやサービスのプラットフォームです。このページは、 プロダクトカテゴリの 「銅の力で除菌するマスク!消臭・冷却・速乾性も備えた高機能「銅ドライマスク」完成!」プロジェクト詳細ページです。





